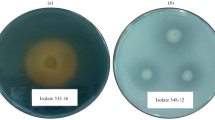

Abstract
Plant growth-promoting rhizobacteria (PGPR) have a positive effect on plant development and being a promising way to enhance crop productivity and as substitution of chemical fertilizers. Selenium (Se) is an important trace element and its intake is usually lower than the daily minimum amount required for humans; hence, there is a demand on the design of Se biofortification strategies. Here, the genetic traits known to be associated with Plant-Growth Promotion (PGP) and Se biotransformation of Exiguobacterium sp. S17 were evaluated through genome analysis. Its growth-promoting capacity was tested through plant-growth promotion assays in laboratory and field conditions, using Brassica juncea (indian mustard), Beta vulgaris (chard), and Lactuca sativa (lettuce). Additionally, the Se biotransformation ability of Exiguobacterium sp. S17 was evaluated and the obtained selenized bacteria were tested in mustard plants. The sequenced bacteria genome revealed the presence of multiple genes involved in important functions regarding soil and plant colonization, PGP and Se biotransformation. Moreover, it was demonstrated that Exiguobacterium sp. S17 enhanced plant growth and could be useful to produce Se accumulation and biofortification in accumulator plants such as mustard. Thereby, Exiguobacterium sp. S17 might be used for developing new, sustainable, and environmentally friendly agro-technological strategies.
Similar content being viewed by others
Avoid common mistakes on your manuscript.
Introduction
Bacteria of the genus Exiguobacterium are commonly found in soil, water, and stromatolite and are characterized by their ability to transform or degrade multiple organic and inorganic toxins (Ordoñez et al. 2013, 2015; Akkoyun et al. 2020). Exiguobacterium strains could be of biotechnological interest due to their diverse functions and possible applications (Chauhan et al. 2015; Kasana et al. 2018). Several studies have focused on different activities relevant to economic and ecological processes, such as bioremediation, heavy metal fortification in crops, and agricultural applications as plant-growth promoters (Kumar et al. 2006; Okeke 2008; Bharti et al. 2013; Kasana and Pandey 2018). In agronomic systems, it has been suggested that Exiguobacterium species may promote plant growth, solubilize phosphate, and produce indole-3-acetic acid (IAA) and exopolysaccharide (EPS) (Dastager et al. 2010; Bharti et al. 2013; Chauhan et al. 2015). In addition to the reported properties, Exiguobacterium strains could be used in new biotechnological processes. For this reason, the present study explored the possible application of Exiguobacterium sp. S17 as a bioinoculant for plant-growth promotion and its utilization in selenium (Se) biofortification strategies in horticultural plants.
In horticultural production and sustainable agriculture, the substitution of chemical fertilizers by plant growth-promoting bacteria (PGPB) is desirable due to the reduction in costs and the low environmental impact. Although the application of fertilizers plays a fundamental role in increasing agricultural production, their excessive use not only causes pollution and a potential risk to humanity but also irreversibly alters the ecology of the soil, further reducing the area available for crop production (Jones et al. 2001; Vejan et al. 2016; Wang et al. 2019). In this sense, the isolation, characterization, and use of plant growth-promoting bacteria as bio-based fertilizers is one of the promising ways to enhance crop productivity and manage plant diseases (Sturz and Nowak 2000; Venkadesaperumal et al. 2014).
Although Se is not essential in plants, it promotes their growth and development (Pilon-Smits and Quinn 2010) and induces the expression of genes related to antioxidant defense and Se-assimilation. Moreover, Se induces the production of polyphenols, which are known to scavenge free radicals and inhibit membrane lipid peroxidation, enhancing plant resistance to oxidative stress (Zahedi et al. 2019). Selenium is also an essential trace element in humans and other vertebrates. It is involved in immune system modulation, cancer prevention, brain development and cognitive aspects, thyroid hormone metabolism, and cardiovascular protection (Beckett and Arthur 2005; Pedrero et al. 2006; Papp et al. 2007; Nicastro and Dunn 2013; Palomo-Siguero and Madrid 2017). In several countries, Se intake is lower than the minimum daily requirement due to the shortage of this element in crop food sources and the low concentration of Se in soils (Combs 2001; Rayman 2008). To overcome this problem, various Se biofortification strategies for different crops have been used, such as exogenous incorporation in ionic forms and, more recently, in the form of nanoparticles (Moreno-Martin et al. 2019). These strategies showed promising results in coping with Se deficiency (Perez et al. 2019). In nature, Se is found as selenide (Se2−), elemental Se (Se0), and soluble salts selenite (SeO2−3) and selenate (SeO2−4), which are the most toxic Se forms (Martínez et al. 2020). Some bacteria can biotransform Se salts into the seleno-amino acids selenomethionine (SeMet) and selenocysteine (SeCys) (Pescuma et al. 2017; Martínez et al. 2020), and into seleno-nanoparticles (SeNPs) containing mainly Se0 (Palomo-Siguero et al. 2016; Moreno-Martín et al. 2020). Organic Se species (such as SeCys and SeMet) and seleno-nanoparticles (SeNPs) are less toxic and can be absorbed and transported by plants more efficiently than Se salts (Moreno-Martin et al. 2020).
The aims of the present work were to analyze the plant growth-promoting capacity and the Se biotransformation ability of Exiguobacterium sp. S17 using genome sequence as a tool to identify the key functions of the bacterial strain and to confirm these activities both in laboratory and field conditions. Additionally, the beneficial effects of the application of selenized Exiguobacterium sp. S17, such as plant growth promotion, micronutrient biofortification, and an increase in Phenolic compounds content and antioxidant activity were evaluated in mustard, a Se secondary accumulator model species.
Materials and methods
Bacterial strain
For this study, bacterial strain Exiguobacterium sp. S17, isolated from Socompa lake stromatolite (Ordoñez et al. 2013) in the high-altitude Andean Puna, was obtained from the culture collection of LIMLA-PROIMI-CONICET. The strain was stored at −20 °C in distilled H2O with 20% (v/v) glycerol. Before performing the assays, cells were transferred to fresh Luria–Bertani (LB) broth (Britania) and cultured overnight (16 h) at 30 °C.
Analysis of genes that contribute to plant-growth promotion and Se biotransformation in Exiguobacterium sp. S17 genome
A comprehensive set of 78 genes coding for known Plant Growth-Promoting Rhizobacteria (PGPR) related proteins and Se metabolism were selected from the literature; their protein sequence IDs were retrieved from genomes of species of the genus Bacillus, using the NCBI Protein and the KEGG databases (B. megaterium QM B1551, B. cereus ATCC 14579, and B. subtilis QB928). Then, other protein sequence IDs were retrieved from the Gram-negative proteobacteria genomes (Burkholderia sp. KJ006, Pseudomonas fluorescens F113, and Pseudomonas aeruginosa PAO1), using the NCBI Batch Entrez. Homolog genes of these proteins/protein sequence were searched using Blastp in Exiguobacterium sp. S17 genome (DDBJ/EMBL/GenBank accession number ASXD01000000, Ordoñez et al. 2013). Only best hits with an E-value cut-off of 1e−05 (≤ 0.00001) were retained. Moreover, proteins were considered to be homologs only if they shared the same Pfam functional protein domains. Protein domain assignment was performed using InterProScan.
Plant-growth promotion assays
The ability of Exiguobacterium sp. S17 to enhance plant growth was first tested in the laboratory under controlled conditions using Brassica juncea (Indian mustard). Indian mustard was chosen as a model species because it is a well characterized and fast growing plant, tolerant to Se, and with the ability to accumulate Se (Hanson et al. 2003). Then, plant growth promotion was tested in a field assay using commercial production conditions. For the field assay, two of the most popular crops and with the largest production area among salad crops in the world were used: Beta vulgaris L. var Bressane (chard) and Lactuca sativa L. var Criolla verde (lettuce).
In the laboratory assay, to evaluate whether Exiguobacterium sp. S17 could actually promote mustard growth, two treatments and two control groups were carried out with 10 replicates (10 independent pots) each. In the first treatment, mustard seeds were immersed in an Exiguobacterium sp. S17 suspension (1.5 × 108 CFU/mL) for 12 h at room temperature and shaking speed of 120 rpm. Bacterial suspensions used in these treatments were grown in Standard Medium 1 broth (ST1) (meat peptone 15 g/L, yeast extract 3 g/L, NaCl 6 g/L and glucose 1 g/l) at pH 7.6 (selected in previous assays as the optimal media) for 48 h at 30 °C. As control groups, mustard seeds were immersed in sterilized water and ST1 broth without any bacteria. Then, ten mustard seeds were sown in each 2-L plastic pot (10 independent pots per treatment) filled with a mixture of soil and volcanic sand (1:1). After 1 week, plants were thinned by leaving three plants per pot. A second set of ten pots with pre-inoculated seeds was prepared for the re-inoculated treatment. In these treatments, plants obtained from seeds immersed in bacterial suspension (as mentioned above) were re-inoculated after 40 days with 100 mL of the corresponding bacterial suspension (1.5 × 108 CFU/mL), directly on plant substrates. At the same time, control groups were irrigated with 100 mL of ST1 media or 100 mL of sterilized water. Plants were grown in a growth chamber with high-pressure sodium (HPS) lamps with a 17/7 h photoperiod at 21 °C, 50 ± 10% relative humidity, and regularly irrigated at field capacity. After 8 weeks, ten plants from each treatment were carefully removed from the pots, cleaned, and dried at 60 °C until constant weight in order to determine dry weight.
In the field assay, to evaluate whether Exiguobacterium sp. S17 could act as a bioinoculant to induce plant-growth promotion in chard and lettuce, a bacterial suspension was applied to both plant species. The study was carried out in the Experimental Organic Orchard of the CIEFAP (Esquel, Chubut Province, Argentina) from November to December 2021. Seeds were immersed in an Exiguobacterium sp. S17 suspension growth in ST1 broth for 12 h at room temperature and shaking speed of 120 rpm (2 × 108 CFU/mL). Control groups were incubated in distilled water or ST1 broth without bacteria for the same period. Seeds were sown directly in soil in continuous rows (60 cm × 12 m) with a density of 15 plants/m2. A drip irrigation system was installed to provide the required water, and weeds were manually removed. Plants obtained from seeds were re-inoculated after 24 days with 370 mL/m2 of the bacterial suspension (2 × 108 CFU/mL) directly on plant substrates. Control plants were watered with distilled water or sterile ST1 broth. After 40 days, ten plants were harvested, cleaned and dried as described above. To evaluate plant growth promotion, five variables were determined: leaf length and width, root length, fresh weight, and dry weight.
Then, for laboratory and field assays, Kruskal–Wallis nonparametric tests and Conover-Inman a posteriori tests were used for all pairwise comparisons (α = 0.016, including Bonferroni correction, assuming chi-square distribution with 2 df). Statistical analyses were performed with SYSTAT 13 software Version 13.00.005 (Systat Software, Inc.).
Selenium biotransformation by Exiguobacterium sp. S17
Optimal microbial growth in the presence of Se was evaluated. Cultures of Exiguobacterium sp. S17, previously grown in LB media broth (pH 7.6), were inoculated at 2% (v/v) in LB broth supplemented with different Na2SeO3 (Sigma-Aldrich Chemical Co., MO, USA) concentrations (0, 10, 20, 40, 80, 160, 320, 640 mg/L of Se) in a microplate at 30 °C and 150 rpm for 48 h. The optimal Na2SeO3 concentration and incubation period were determined when the deepest red color of the cultures was observed and cell growth inhibition was detected.
Additionally, to evaluate the uptake of Se and the Se biotransformation ability of Exiguobacterium sp. S17, the bacterium was grown in LB broth with or without 160 mg/L of Se at 30 °C and at a shaking speed of 150 rpm for 48 h. Concentration of total Se in the cell pellets was determined by Inductively Coupled Plasma Mass Spectrometry (ICP-MS) after total digestion of the samples in closed vessels containing 1 mL of concentrated HNO3 and 0.5 mL of H2O2 30% (v/v), using a microwave oven (MSP microwave oven, CEM, Matthews, NC, USA). The resulting solutions were cooled down, diluted to a 25 mL final volume with MilliQ water, and further analyzed for Se concentration with a Perkin Elmer NexION 350X ICP-MS with hydrogen gas as collision gas in Centro de Estudios Fotosintéticos y Bioquímicos (CEFOBI)-CONICET, Rosario, Argentina. Finally, the presence of the seleno-nanoparticles (SeNPs) produced by Exiguobacterium sp. S17 was observed by Transmission Electron Microscopy (TEM FEI TECNAI F20 G2) at Laboratorio de Microscopía de Física de Materiales, Centro Atómico Bariloche, Comisión Nacional de Energía Atómica. Samples were prepared by placing a drop of culture onto 300-mesh lacey carbon copper TEM grids. The film on the TEM grids was dried for 5 min at room temperature before analysis. The diameter of SeNPs was measured from the TEM images by using the image-processing software ImageJ 1.52 (Wayne Rasband, National Institutes of Health, USA; website: https://imagej.nih.gov/ij/).
Effect of selenized Exiguobacterium sp. S17 on plant growth, Se and nutrient accumulation, total phenolic compound concentration, and antioxidant activity
To analyze the plant growth-promoting capacity of selenized bacterium, Exiguobacterium sp. S17 was grown in LB media or in LB media with Se (160 mg/L), at 30 °C and 150 rpm, for 48 h. Then, cells were washed twice and suspended in distilled water. Mustard plants were inoculated in soil with 50 mL of a Exiguobacterium sp. S17 (3.1 × 109 cfu/mL) or selenized Exiguobacterium sp. S17 cells (3.1 × 109 cfu/mL containing 1 mg/L of Se as SeNPs or organic Se) in distilled water. A second control group was treated with sterile water. In all treatments, ten replicates were carried out (one pot per replicate, three plants per pot). The plant growth-promoting assay was performed as described above.
To evaluate the increase in micronutrient uptake and accumulation (including Se) by mustard plants, two composite samples per treatment (six plants) were analyzed. Each composite sample was obtained by combining three dried mustard plants from two pots. Samples were homogenized, and 0.2 g was digested, diluted with MilliQ water, and further analyzed by ICP-MS as described above. The micronutrients evaluated were Se, iron (Fe), zinc (Zn), manganese (Mn), copper (Cu), magnesium (Mg), calcium (Ca), and molybdenum (Mo). For macronutrients uptake and accumulation, three composite samples per treatment (nine plants) were analyzed, and nitrogen (N), phosphorus (P)and potassium (K) were measured. Nitrogen was evaluated by material digestion and determination by distillation and manual titration. P and K were calculated using calcination and determination by flame photometry. Techniques for N, P and K were carried out following Sadzawka et al. 2007.
Phenolic compounds were extracted from three dried mustard plants from each pot (3 pots). Plants were homogenized, suspended in methanol/formic acid (97:3 v/v), and incubated for 16 h at room temperature with agitation speed of 60 rpm. A centrifugation step was used to separate the supernatant with two washing steps of the residue (4 h incubation each) with the same solvent. The extract was stored at 4 °C. To determine the total phenolic content of the plant extracts, the modified Folin-Ciocalteu method described by (Crespo et al. 2021) was applied. Briefly, each extract (10 µl) was mixed with Folin-Ciocalteu reagent (50 µl). The mixture was allowed to stand at room temperature for 2 min. Sodium carbonate was added to the mixture (150 µl, 2% w/v), and the total volume was adjusted to 750 µl with distilled water and then mixed gently. After the mixture stood at room temperature for 20 min, the absorbance was measured at 760 nm using a Microplate Reader (Multiskan ™ SkyHigh—Thermo Scientific). The standard calibration curve was plotted using gallic acid (2.5–100 µg/mL). The total phenolic content was expressed as mg gallic acid equivalents (GAE) per g of dried biomass.
The antioxidant capacity of extracts obtained from control plants and from plants inoculated with Exiguobacterium sp. S17 or with Exiguobacterium sp. S17 with Se (SeNPs) was determined by applying the DPPH, ABTS (TEAC), and FRAP methods. The DPPH radical scavenging capacity was evaluated according to the method of Isas et al. (2020). To perform this technique, mustard plant extracts were diluted 1/100 (v/v). The DPPH radical scavenging activity was calculated using the following equation:
where Ab is the absorbance of the blank reaction (all reagents except mustard extract), and As is the absorbance of the sample (subtracting the absorbance of the sample with DPPH from the one without DPPH).
The Trolox Equivalent Antioxidant Capacity (TEAC) method was performed according to Re et al. (1999), based on the capacity of a sample to inhibit the 2,2′-azino-bis-(3-ethylbenzothiazoline-6-sulfonic acid) radical (ABTS•+) in comparison with a reference antioxidant standard (Trolox). For performing this technique, the samples were diluted 1/1000 to enter the Trolox calibration curve (50–250 µM). Results were expressed as Trolox equivalent per gram of dried biomass.
Ferric-reducing power was determined according to Kozarski et al. (2011) with some modifications. The samples were diluted 1/10 and mixed with 0.25 mL 0.2 M sodium phosphate buffer (pH 6.6) and 0.25 mL of 1% potassium ferricyanide. The mixture was vortexed and incubated at 50 °C for 20 min. Then, 0.25 mL of 10% trichloroacetic acid (w/v) was added, and 0.5 mL of the mixture was mixed with 0.5 mL of distilled water and 0.1 mL of 0.1% ferric chloride. The absorbance of 0.2 mL was measured at 700 nm against a blank using a UV/Vis spectrophotometer (Multiskan Sky High, Thermo Scientific, Waltham, Massachusetts, USA). The blank was the solution with all reagents but without the mustard extracts. A higher absorbance indicates a higher reducing power. Results were expressed as ascorbic acid equivalents per g of dried biomass.
Results
Analysis of genes that contribute to plant-growth promotion and Se biotransformation in Exiguobacterium sp. S17 genome
To determine whether the Exiguobacterium sp. S17 strain displayed one or several of the genetic traits known to be associated with Plant-Growth Promotion (PGP), or with Se biotransformation, its sequenced genome was analyzed. Briefly, with the data identified from the literature and database searches, a detailed list of PGP-related genes and their associated protein sequences was done. Results of this analysis revealed that the genome of Exiguobacterium sp. S17 encodes a complete set of proteins involved in PGP activity linked to phosphate solubilization and mineralization, nitrogen assimilation, reduction, and fixation, siderophore synthesis, Fe-uptake, flagellar assembly, bacterial chemotaxis, and synthesis of several compounds (l-tryptophan, indole, auxin, spermidine, acetoin butanediol nitric oxide and exopolysaccharide) (Table 1). Additionally, the genome of Exiguobacterium sp. S17 encodes genes involved in the formation of SeNPs and selenoprotein synthesis: glutathione reductase, thioredoxin reductase, methyl-tRNA synthase, selenocysteine lyase, cysteine-S-conjugate beta–lyase, methionyl-tRNA synthase.
Plant-growth promotion assays
The comparison between the dry weight of mustard seedlings subjected to different treatments (simple and double inoculation) and the control groups showed statistical differences (KW = 19.237, p = 0.001). Seedlings with double inoculation of Exiguobacterium sp. S17 had significantly greater dry weight than seedlings from the control group and from the groups with single and double inoculations with culture medium (p < 0.009) (Fig. 1). Mustard seedlings with reinoculation showed a mean dry weight of 1.4 g, whereas the mean dry weight of the control group (non-inoculated) was 0.71 g. Single-inoculated seeds, without reinoculation, showed a slightly lower growth than the control groups (KW = 2,509 p = 0,016) and much lower growth in comparison with seedlings with double inoculation (KW = 5.696, p = 0,000) (Fig. 1). Culture media had no effect on plant growth (p > 0.213).
Plant-growth promotion of mustard seedlings (measure as dry biomass) after simple and double inoculation with Exiguobacterium sp. S17. Control: seedlings watered with distilled water. St1: seedlings watered with culture medium. St1 × 2: seedlings with a double inoculation of culture medium. sp17: seedlings pre-inoculated with Exiguobacterium sp. S17. sp17 × 2: seedlings with a re-inoculation of Exiguobacterium sp. S17. Different letters indicate significant statistical differences
Similarly, Exiguobacterium sp. S17 inoculation significantly promoted plant growth in comparison with the control group under field conditions. The inoculation with the bacterial strain in chard produced an increment in most of the measured variable in leaves and roots. Increases of 39% in leaf length (K = 12.143, p = 0.002), 156% in leaf fresh weight (K = 9.857, p = 0.007), and 211% in leaf dry weight (K = 10.035, p = 0.007) were observed. Roots were 49% longer (K = 10.574, p = 0.005) and their weight (dry and fresh) was 168% and 177.6% greater than in the control group rinsed with water and ST1 medium (K = 8.909, p = 0.012 and K = 9.323, p = 0.009, respectively) (Fig. 2a, b, c, d). Regarding lettuce, the effect of Exiguobacterium sp. S17 was observed only in leaves. The leaves were 35.2% longer (K = 9.975, p = 0.007) and 53.2% wider (K = 8.250, p = 0.016) than in control plants, and fresh and dry weights were 196% and 154% greater than in the control group (K = 9.890, p = 0.007 and K = 8.674, p = 0.013) (Fig. 2e, f, g, h).
Effect of selenized Exiguobacterium sp. S17 on plant growth, Se and nutrient accumulation, total phenolic compounds concentration, and antioxidant activity
Exiguobacterium sp. S17 was able to grow in LB broth at different Se concentrations, and the deeppest reddish color was obtained at a concentration of 160 mg/L; however, growth after 48 h incubation was 1 U log lower than in the control LB media. The Se concentration in the cell pellets in the presence of Se was 19.4 mg/L, and in the control cells 0.002 mg/L. Exiguobacterium sp. S17 produced irregular and spherical SeNPs with a diameter of 0.146 µm ± 0.052 (Fig. 3a, b, c), and the three emission peaks of Se [Lα (1.4 keV), Kα (11.22 keV), and Kβ (12.49 keV)] were confirmed by XEDS (Fig. 3c).
a–b TEM images and for the SeNPs produced by Exiguobacterium sp. S17 (some SeNPs are marked with circles and S17 cells are marked with arrows), c histogram showing SeNPs size and d XEDS analysis graph depicting energy on X-axis and number of counts on Y-axis representing elemental composition derived from SeNPs selected areas. Arrows in XEDS spectra indicate the Se emission peaks consisting of SeLα, SeKα, and SeKβ at 1.4, 11.22, and 12.49 keV, respectively
Selenized cells of Exiguobacterium sp. S17 inoculation had a positive effect on fresh weight of mustard plants (K = 10.640, p = 0.005). A significant increase of 28% in the fresh weight with respect to the control group (p = 0.015) and 46% in comparison with plants pre-inoculated with Exiguobacterium sp. S17 (p = 0.007) was observed. However, differences in dry weight were not significant between plants inoculated with the selenized cells (SeNPs) and control plants (p = 0.079) or between plants inoculated with control Exiguobacterium cells compared with the control group (p = 0.136). Plants inoculated with non-selenized bacteria showed significantly lower growth than plants treated with the selenized Exiguobacterium sp S17 cells (p = 0.002) (Fig. 4a). Moreover, an increase in root growth was detected in the SeNPs samples compared to the control group (Fig. 4b). Besides the plant growth-promoting effect, Se concentration in the SeNPs inoculated plants was at least 7.8 fold higher than in the control plants (Table 2), while an increase in the concentration of Fe and Mn, and an subtle reduction of Cu were also observed (Table 2).
Total phenolic content (TPC), DPPH radical scavenging activity (RSA), total Trolox equivalent antioxidant capacity (TEAC) and Ferric-reducing antioxidant power (FRAP) were significantly different among treatments (p ≤ 0.016, Table 3). The total phenolic compound concentration in the mustard plants with SeNPs was greater than in the plants of the control group and those inoculated with Exiguobacterium sp. S17 alone. In comparison with the control group, selenized plants showed a 27% increase in phenolic concentration, and plants inoculated with non-selenized bacteria exhibited an 18% increase (Table 3). The antioxidant capacity determined by the DPPH was slightly higher in the plants inoculated with SeNPs. However, the FRAP values in SeNPs-treated plants were significantly higher than those obtained from the control and Exiguobacterium sp. S17 inoculated plants (Table 3). Furthermore, the antioxidant activity measured by ABTS (TEAC) in plants inoculated with Exiguobacterium sp. S17 and SeNPs was also higher than the TEAC in the control plants.
Discussion
In the present study, Exiguobacterium sp. S17 was evaluated in its ability to promote plant growth in different species and to produce Se biotransformation and Se accumulation and biofortification in mustard plants. Assays carried out in this study revealed that this bacterial strain possesses all these capabilities and, then, it could be used as a PGPR and in biofortification strategies.
In order to confirm the plant growth-promoting capacities of Exiguobacterium sp. S17, plants under field conditions were inoculated and the results revealed that Exiguobacterium sp. S17 displays evident plant growth-promoting activities, mainly in leafy greens such as chard and lettuce. The increase in leaf and root biomass and size is in agreement with previous studies which demonstrated that other strains in the genus Exiguobacterium also play an important role in plant-growth promotion (Dastager et al. 2010; Selvakumar et al. 2010; Bharti et al. 2013).
Analysis of the whole genome of Exiguobacterium sp. S17 supports the positive effect found on plant growth. It is well known that PGPR promote plant growth by providing nutrients to the host plant or by preventing infections by pathogenic organisms (Castro-Sowinski et al. 2007; Glick 2012). Examples of the supply of extra nutrients include nitrogen fixation, which provides reduced nitrogen; the production of phytohormones, which increases root surface area for absorption of nutrients; siderophores, which capture and solubilize iron; and organic acids, which solubilize phosphates (Lifshitz et al. 1987; Vessey 2003; Santoyo et al. 2016; Liu et al. 2017). In this sense, genes involved in the supply of nutrients have been found, such as those linked to phosphate solubilization and mineralization, nitrogen assimilation and reduction, nitrogen fixation, siderophore synthesis, and Fe-uptake. Biological nitrogen fixation and phosphorus uptake, together with microbial production of phytohormones, were the major factors responsible for plant-growth improvement by PGPR, which contributes to the development of an efficient root system with enhanced water and nutrient uptake (Lifshitz 1987; Ahmed and Hasnain 2014). The genome sequence suggests that Exiguobacterium sp. S17 has the capability to synthesize phytohormones like auxin (Indole-3-Acetic acid), spermidine, cetoin, utanediol, and nitric oxide (NO). Auxins, as well as NO as an intermediary in auxin‐regulated signaling cascade, control most of plant processes and, for this reason, they are considered responsible for most of the developmental patterns in plants (Tanimoto 2005; Molina‐Favero 2007; Wu et al. 2011). PGPR produces auxins and NO regulates root development, stimulating root formation and lateral root initiation, along with the growth of new leaves at the apical meristem (Molina‐Favero 2007; Ahmed and Hasnain 2014). Polyamines, including putrescine, spermine, spermidine, and cadaverine, are natural small-molecular-weight polycationic compounds that are present in mammals, fungi, bacteria, and plants. Polyamines play important physiological roles in organisms and are involved in various processes, including cell division and differentiation, nucleic acid replication, transcription, translation, protein synthesis, and membrane stability (Kusano et al. 2008). Moreover, spermidine has attracted widespread interest because it is essential for eukaryotic cell viability, and its presence is correlated with lateral root development (Xie et al. 2014). Previous studies showed that spermidine was the pivotal plant growth-promoting substance produced by B. subtilis OKB105, by inducing expansin expression and decreasing root-inhibiting factors like ethylene in plant cells (Xie et al. 2014). Exiguobacterium sp. S17 genome showed the presence of genes involved in the synthesis of air-borne chemicals that are released from specific bacterial strains able to trigger growth promotion and induce systemic resistance (ISR), such as acetoin (which was found to trigger ISR and protect plants against pathogens) and butanediol synthesis (Ryu et al. 2003; Rudrappa et al. 2010). Lastly, the capacity of rhizobacteria to migrate towards the roots and colonize them in response to root exudates also requires a set of genes, including some involved in flagellar biosynthesis/regulation that were also found in the Exiguobacterium sp. S17 genome (Cole et al. 2017).
Selenium is a metalloid considered a vital micronutrient in the human diet. Selenium replaces sulfur in cysteine and it is incorporated as selenocysteine (SeCys) in selenoproteins (Mounicou et al. 2006). The main selenoenzymes are glutathione peroxidase, iodothyronine deiodinase, and thioredoxin reductase, which are involved in antioxidant defense, detoxification, and thyroid functions (Palomo-Siguero and Madrid 2017). Selenium deficiency in humans is associated with hypothyroidism, cardiovascular disease, and immune system weakness (Pedrero et al. 2006). However, there is a fine line between Se essentiality and toxicity. Bacteria have a specific scavenging, uptake, and removal system for many elements including Se. Selenium is found within the biosphere in all its oxidation states but mainly as Se VI and Se IV, which are highly toxic. Elemental Se is less toxic and water-insoluble and many bacteria can bio-transform Se salts into less toxic Se0 containing nanoparticles as a detoxifying mechanism that will affect its Se resistance capacity. Exiguobacterium sp. S17 was able to incorporate and transform Se into irregular and spherical seleno-nanoparticles (SeNPs). Different mechanisms have been proposed to be involved in selenite reduction by microorganisms. Thiol-mediated Se reduction is the most widely recognized mechanism and involves glutathione and a NADPH-dependent reductase. However, others include the thioredoxin reductase system and siderophore-mediated reduction. Reduced thioredoxin can react with selenodiglutathione and form oxidized thioredoxin, reduced glutathione and selenopersulfide anion from which Se0 is released. In addition, an iron siderophore produced by Pseudomonas stutzeri KC was proposed to be responsible for selenite reduction to Se0. Although the mechanism by which Exiguobacterium sp: S17 produces SeNPs has not been elucidated, this mechanism could be responsible for Se0 formation and SeNPs production. Moreover, the presence of the gene coding for a selenocysteine lyase could also be involved in Se0 production from selenocysteine. Besides, the enzymes cysteine S-conjugate beta lyase and methionyl tRNA synthase in selenoprotein synthesis were also found in Exiguobacterium sp. S17 genome. The SeNPs produced by the analyzed bacteria showed a moderate effect on the growth of mustard roots and leaves. Mustard plants inoculated with SeNPs showed a moderate increase in fresh weight of 46% whereas differences in dry weight were not observed. In addition to the plant growth promotion effect, Se concentration in the SeNPs inoculated plants was far greater than in the control plants, suggesting that biofortification using selenized bacteria is feasible. Additionally, an increase in the concentration of Fe and Mn was also observed in SeNPs-inoculated plants suggesting that SeNPs improve the essential element uptake by mustard plants. Similar results were observed for wheat when Se was added to their leaves (Nawaz et al. 2015) and also when SeNPs were foliar applied to pomegranate plants (Zahedi et al. 2019).
Finally, SeNPs inoculation increased the antioxidant capacity of plants as measured by DPPH and FRAP, and the total phenolic was also higher in the SeNPs inoculated mustard plants. Similar results were observed by Zahedi et al. (2019), who found significant differences in anthocyanin concentration and antioxidant activity by foliar applying SeNPs to pomegranate plants. Consistently, Badawy et al. (2017) found that Se fertilizer significantly increased the total polyphenol content in several plant species.
Conclusion
Exiguobacterium sp. S17 showed two capabilities that make this bacterial strain a candidate to be applied in a bioinoculant formulation. On the one hand, the application in soil of Exiguobacterium sp. S17 produced high plant-growth promotion in leafy greens such as chard and lettuce. On the other hand, selenized Exiguobacterium sp. S17 could be useful to produce Se accumulation and biofortification in accumulator plants to be used as dietary supplement. Finally, this biofortification increase antioxidant capacity and improves the nutritional value of horticultural plants.
Data availability
The datasets generated during and analysed during the current study are available in DDBJ/EMBL/GenBank under accession number ASXD01000000 or from the corresponding author on reasonable request.
References
Ahmed A, Hasnain S (2014) Auxins as one of the factors of plant growth improvement by plant growth promoting rhizobacteria. Pol J Microbiol 63:261
Akkoyun MB, Özdemir S, Kılınç E, Birhanlı E (2020) Investigations of Hg (II) and Pb (II) tolerance, removal and bioaccumulation and their effects on antioxidant enzymes on thermophilic Exiguobacterium profundum. Hum Ecol Risk Assess 26:1234–1253
Badawy EM, Hanafy AH, Emano E, Ahmed SS, Laura P, Fouad H (2017) Effect of salinity, selenium and boron on chemical composition of Brassica napus L. plants grown under sandy soil conditions. Res J Pharm Biol Chem Sci 8:2645–2655
Beckett GJ, Arthur JR (2005) Selenium and endocrine systems. J Endocrinol 184:455–465. https://doi.org/10.1677/joe.1.05971
Bharti N, Yadav D, Barnawal D, Maji D, Kalra A (2013) Exiguobacterium oxidotolerans, a halotolerant plant growth promoting rhizobacteria, improves yield and content of secondary metabolites in Bacopa monnieri (L.) Pennell under primary and secondary salt stress. World J Microbiol Biotechnol 29:379–387
Castro-Sowinski S, Herschkovitz Y, Okon Y, Jurkevitch E (2007) Effects of inoculation with plant growth-promoting rhizobacteria on resident rhizosphere microorganisms. FEMS Microbiol Lett 276:1–11
Chauhan H, Bagyaraj DJ, Selvakumar G, Sundaram SP (2015) Novel plant growth promoting rhizobacteria—Prospects and potential. Appl Soil Ecol 95:38–53
Cole BJ, Feltcher ME, Waters RJ, Wetmore KM, Mucyn TS, Ryan EM et al (2017) Genome-wide identification of bacterial plant colonization genes. PloS Biol 15:e2002860. https://doi.org/10.1371/journal.pbio.2002860
Combs GF (2001) Selenium in global food systems. Br J Nutr 85:517–547. https://doi.org/10.1079/BJN2000280
Crespo L, Gaglio R, Martínez FG, Martin GM, Franciosi E, Madrid-Albarrán Y, Settanni L, Mozzi F, Pescuma M (2021) Bioaccumulation of selenium-by fruit origin lactic acid bacteria in tropical fermented fruit juices. LWT 151:112103
Dastager SG, Kumaran DC, Pandey A (2010) Characterization of plant growth-promoting rhizobacterium Exiguobacterium NII-0906 for its growth promotion of cowpea (Vigna unguiculata). Biologia 65:197–203
Glick BR (2012) Plant growth-promoting bacteria: mechanisms and applications. Scientifica 2012. https://doi.org/10.6064/2012/963401
Hanson B, Garifullina GF, Lindblom SD, Wangeline A, Ackley A, Kramer K, Norton AP, Lawrence CB, Pilon-Smits EA (2003) Selenium accumulation protects Brassica juncea from invertebrate herbivory and fungal infection. New Phytol 159:461–469. https://doi.org/10.1046/j.1469-8137.2003.00786.x
Isas AS, Celis MSM, Correa JRP, Fuentes E, Rodríguez L, Palomo I, Mozzi F, Van Nieuwenhove C (2020) Functional fermented cherimoya (Annona cherimola Mill.) juice using autochthonous lactic acid bacteria. Food Res Int 138:109729
Jones WJ, Ananyeva ND (2001) Correlations between pesticide transformation rate and microbial respiration activity in soil of different ecosystems. Biol Fertil Soils 33:477–483. https://doi.org/10.1007/s003740100365
Kasana RC, Pandey CB (2018) Exiguobacterium: an overview of a versatile genus with potential in industry and agriculture. Crit Rev Biotechnol 38:141–156. https://doi.org/10.1080/07388551.2017.1312273
Kozarski M, Klaus A, Niksic M, Jakovljevic D, Helsper JP, Van Griensven LJ (2011) Antioxidative and immunomodulating activities of polysaccharide extracts of the medicinal mushrooms Agaricus bisporus, Agaricus brasiliensis, Ganoderma lucidum and Phellinus linteus. Food Chem 129:1667–1675
Kumar A, Singh V, Kumar R (2006) Characterization of an alkaliphile, Exiguobacterium sp. and it’s application in bioremediation. In Book of Abstracts: Proc. Int. Conf. on Extremophiles, p 115.
Kusano T, Berberich T, Tateda C, Takahashi Y (2008) Polyamines: essential factors for growth and survival. Planta 228:367–381
Lifshitz R, Kloepper JW, Kozlowski M, Simonson C, Carlson J, Tipping EM, Zaleska I (1987) Growth promotion of canola (rapeseed) seedlings by a strain of Pseudomonas putida under gnotobiotic conditions. Can J Microbiol 33:390–395. https://doi.org/10.1139/m87-068
Liu H, Carvalhais LC, Crawford M, Singh E, Dennis PG, Pieterse CMJ et al (2017) Inner plant values: diversity, colonization and benefits from endophytic bacteria. Front Microbiol 8:2552. https://doi.org/10.3389/fmicb.2017.02552
Martínez FG, Moreno-Martin G, Pescuma M, Madrid-Albarrán Y, Mozzi F (2020) Biotransformation of selenium by lactic acid bacteria: formation of seleno-nanoparticles and seleno-amino acids. Front Bioeng Biotechnol 8:506
Molina-Favero C, Creus CM, Lanteri ML, Correa-Aragunde N, Lombardo MC, Barassi CA, Lamattina L (2007) Nitric oxide and plant growth promoting rhizobacteria: common features influencing root growth and development. Adv Bot Res 46:1–33. https://doi.org/10.1016/S0065-2296(07)46001-3
Moreno-Martin G, Sanz-Landaluze J, León-Gonzalez ME, Madrid Y (2019) In-vivo solid phase microextraction for quantitative analysis of volatile organoselenium compounds in plants. Anal Chim Acta 1081:72–80. https://doi.org/10.1016/j.aca.2019.06.061
Moreno-Martín G, Sanz-Landaluze J, León-González ME, Madrid Y (2020) Insights into the accumulation and transformation of Ch-SeNPs by Raphanus sativus and Brassica juncea: Effect on essential elements uptake. Sci Total Environ 725:138453. https://doi.org/10.1016/j.scitotenv.2020.138453
Mounicou S, Vonderheide AP, Shann JR, Caruso JA (2006) Comparing a selenium accumulator plant (Brassica juncea) to a non-accumulator plant (Helianthus annuus) to investigate selenium-containing proteins. Anal Bioanal Chem 386:1367–1378
Nawaz F, Ashraf AR, MY, Waraich EA, Khan SZ, (2015) Effect of selenium foliar spray on physiological and biochemical processes and chemical constituents of wheat under drought stress. Ecotoxicol Environ Saf 113:191–200. https://doi.org/10.1016/j.ecoenv.2014.12.003
Nicastro HL, Dunn BK (2013) Selenium and prostate cancer prevention: insights from the selenium and vitamin E cancer prevention trial (SELECT). Nutrients 5:1122–1148
Okeke BC (2008) Bioremoval of hexavalent chromium from water by a salt tolerant bacterium, Exiguobacterium sp. GS1. Front Bioeng Biotechnol 35:1571–1579
Ordoñez OF, Lanzarotti E, Kurth D, Gorriti MF, Revale S, Cortez N, Vazquez MP, Farías MP, Turjanski AG (2013) Draft genome sequence of the polyextremophilic Exiguobacterium sp. strain S17, isolated from hyperarsenic lakes in the Argentinian Puna. Genome Announc 1:e00480-e513
Ordoñez OF, Lanzarotti EO, Kurth DG, Cortez N, Farias ME, Turjanski AG (2015) Genome comparison of two Exiguobacterium strains from high altitude andean lakes with different arsenic resistance: identification and 3D modeling of the Acr3 efflux pump. Front Environ Sci 3:50
Palomo-Siguero M, Madrid Y (2017) Exploring the behavior and metabolic transformations of SeNPs in exposed lactic acid bacteria. Effect of nanoparticles coating agent. Int J Mol Sci 18:1712. https://doi.org/10.3390/ijms18081712
Palomo-Siguero M, Gutiérrez AM, Pérez-Conde C, Madrid Y (2016) Effect of selenite and selenium nanoparticles on lactic bacteria: a multi-analytical study. Microchem J 126:488–495
Papp LV, Lu J, Holmgren A, Khanna KK (2007) From selenium to selenoproteins: synthesis, identity, and their role in human health. Antioxid Redox Signal 9:775–806
Pedrero Z, Madrid Y, Cámara C (2006) Selenium species bioaccessibility in enriched radish (Raphanus sativus): a potential dietary source of selenium. J Agric Food Chem 54:2412–2417. https://doi.org/10.1021/jf052500n
Pérez MB, Lipinsk VM, Filippini MF, Chacón-Madrid K, Arruda MAZ, Wuilloud RG (2019) Selenium biofortification on garlic growth and other nutrients accumulation. Hortic Bras 37:294–301
Pescuma M, Gomez-Gomez B, Perez-Corona T, Font G, Madrid Y, Mozzi F (2017) Food prospects of selenium enriched-Lactobacillus acidophilus CRL 636 and Lactobacillus reuteri CRL 1101. J Funct Foods 35:466–473. https://doi.org/10.1016/j.jff.2017.06.009
Pilon-Smits EA, Quinn CF (2010) Selenium metabolism in plants. In Cell biology of metals and nutrients. Springer, Berlin, Heidelberg, pp 225–241
Rayman MP (2008) Food-chain selenium and human health: emphasis on intake. Br J Nutr 100:254–268. https://doi.org/10.1017/S0007114508939830
Re R, Pellegrini N, Proteggente A, Pannala A, Yang M, Rice-Evans C (1999) Antioxidant activity applying an improved ABTS radical cation decolorization assay. Free Radic Biol Med 26:1231–1237
Rudrappa T, Biedrzycki ML, Kunjeti SG, Donofrio NM, Czymmek KJ, Paul WP, Bais HP (2010) The rhizobacterial elicitor acetoin induces systemic resistance in Arabidopsis thaliana. Commun Integr Biol 3:130–138
Ryu CM, Farag MA, Hu CH, Reddy MS, Pare PW, Kloepper JW (2003) Volatiles produced by PGPR elicit plant growth promotion and induced resistance in Arabidopsis. In proceedings of the sixth international workshop on plant growth promoting Rhizobacteria. pp 436–443.
Sadzawka A, Carrasco M, Demanet R, Flores H, Grez R, Mora ML, Neaman A (2007) Métodos de análisis de tejidos vegetales. Serie Actas INIA 40:140
Santoyo G, Moreno-Hagelsieb G, Orozco-Mosqueda Mdel C, Glick BR (2016) Plant growth-promoting bacterial endophytes. Microbiol Res 183:92–99. https://doi.org/10.1016/j.micres.2015.11.008
Selvakumar G, Kundu S, Joshi P, Nazim S, Gupta AD, Gupta HS (2010) Growth promotion of wheat seedlings by Exiguobacterium acetylicum 1P (MTCC 8707) a cold tolerant bacterial strain from the Uttarakhand Himalayas. Indian J Microbiol 50:50–56
Sturz AV, Nowak J (2000) Endophytic communities of rhizobacteria and the strategies required to create yield enhancing associations with crops. Appl Soil Ecol 15:183–190
Tanimoto E (2005) Regulation and root growth by plant hormones roles for auxins and gibberellins. Critical Rev Plant Sci 24:249–265
Vejan P, Abdullah R, Khadiran T, Ismail S, Nasrulhaq Boyce A (2016) Role of plant growth promoting rhizobacteria in agricultural sustainability—a review. Molecules 21:573
Venkadesaperumal G, Amaresan N, Kumar K (2014) Plant growth promoting capability and genetic diversity of bacteria isolated from mud volcano and lime cave of Andaman and Nicobar Islands. Braz J Microbiol 45:1271–1281
Vessey JK (2003) Plant growth promoting rhizobacteria as biofertilizers. Plant Soil 255:571–586. https://doi.org/10.1023/A:1026037216893
Wang F, Zhou T, Zhu L, Wang X, Wang J, Wang J, Du Z, Li B (2019) Effects of successive metalaxyl application on soil microorganisms and the residue dynamics. Ecol Indic 103:194–201. https://doi.org/10.1016/j.ecolind.2019.04.018
Wu HM, Hazak O, Cheung AY, Yalovsky S (2011) RAC/ROP GTPases and auxin signaling. Plant Cell 23:1208–1218
Xie SS, Wu HJ, Zang HY, Wu LM, Zhu QQ, Gao XW (2014) Plant growth promotion by spermidine-producing Bacillus subtilis OKB105. Mol Plant-Microbe Interact 27:655–663
Zahedi SM, Hosseini MS, Meybodi NDH, Teixeira da Silva JA (2019) Foliar application of selenium and nano-selenium affects pomegranate (Punica granatum cv. Malase Saveh) fruit yield and quality. S Afr J Bot 124:350–358
Acknowledgements
The authors are deeply grateful to Lic. Romina Cangelosi for kindly supplying us with seeds and for her valuable assistance in experiments in field conditions.
Funding
This work was supported by the Agencia Nacional de Promoción Científica y Técnica of Argentina (grant number ANPCyT/FONCyT/PICT PICT-2019-03437 and ANPCyT/FONCyT /PICT 2020-Serie A-02869) and by Centro de Investigación y Extensión Forestal Andino Patagónico (CIEFAP-Proyecto estratégico Producción de Biofungicidas y bio-inoculantes P6-M7-SM2).
Author information
Authors and Affiliations
Contributions
Conceptualization: MJA, GAL, FME, VML, PM and OOF. Methodology: MJA (Bacterial production, Plant-growth promotion assays, Effect of selenized Exiguobacterium sp. S17 on plant growth), GAL (Plant-growth promotion assays, total phenolic compound concentration, and antioxidant activity), PM (Selenium biotransformation, Se and micronutrient accumulation, total phenolic compound concentration, and antioxidant activity) and OOF (Analysis of genes in Exiguobacterium sp. S17 Genome, Selenium biotransformation by Exiguobacterium sp. S17, Effect of selenized Exiguobacterium sp. S17 on plant growth). Statistical analysis and Data curation: MJA, GAL, VML. Writing-original draft preparation: MJA, VML. Writing—review and editing: All authors. Funding acquisition: MJA, VML, PM and OOF. Resources: FME, VML, OOF. Supervision: VML.
Corresponding authors
Ethics declarations
Competing interest
The authors declare no competing interest.
Additional information
Publisher's Note
Springer Nature remains neutral with regard to jurisdictional claims in published maps and institutional affiliations.
Rights and permissions
Springer Nature or its licensor (e.g. a society or other partner) holds exclusive rights to this article under a publishing agreement with the author(s) or other rightsholder(s); author self-archiving of the accepted manuscript version of this article is solely governed by the terms of such publishing agreement and applicable law.
About this article
Cite this article
Marfetán, J.A., Gallo, A.L., Farias, M.E. et al. Exiguobacterium sp. as a bioinoculant for plant-growth promotion and Selenium biofortification strategies in horticultural plants. World J Microbiol Biotechnol 39, 134 (2023). https://doi.org/10.1007/s11274-023-03571-x
Received:
Accepted:
Published:
DOI: https://doi.org/10.1007/s11274-023-03571-x